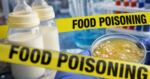

وتختلف الاحتياجات اليومية من البروتين باختلاف العمر والجنس ومستوى النشاط البدني والحالة الصحية، إلا أن معظم البالغين يُنصحون بالحصول على ما بين 10 بالمئة و35 بالمئة من إجمالي سعراتهم الحرارية اليومية من البروتين.
الاحتياجات اليومية من البروتين
تنشر وزارة الزراعة الأميركية (USDA) الإرشادات الغذائية للأميركيين كل 5 سنوات، وتشير التوصيات الصادرة عام 2026 إلى أن البالغين ينبغي أن يستهدفوا استهلاك ما بين 1.2 و1.6 غرام من البروتين لكل كيلوغرام من وزن الجسم، أي ما يقارب ضعف التوصية السابقة التي كانت تبلغ 0.8 غرام/كغ.
وتركّز الإرشادات المحدثة على نطاق أوسع من المغذيات الكبرى، وعلى رأسها البروتين، بهدف دعم “الكفاية الغذائية”، مقارنة بالإرشادات السابقة التي ركزت بشكل أساسي على الحد الأدنى من الاستهلاك لتفادي نقص العناصر الغذائية.
عوامل تؤثر في احتياجات البروتين
تؤثر الخصائص الجسدية ونمط الحياة في كمية البروتين التي يحتاجها الجسم، ومن أبرز هذه العوامل:
- النشاط البدني: الأشخاص النشطون بدنيًا قد يحتاجون إلى كميات أكبر من البروتين لبناء العضلات والحفاظ عليها.
- العمر: يحتاج كبار السن إلى كميات كافية من البروتين للمساعدة في إبطاء فقدان الكتلة العضلية المرتبط بالتقدم في السن.
- الأهداف الصحية: قد تساعد الأنظمة الغذائية الغنية بالبروتين في إنقاص الوزن أو الحفاظ عليه.
- الحالات الطبية: بعض الحالات، مثل مرض الكلى المزمن، قد تستدعي تقليل استهلاك البروتين.
- الحمل: تزداد الاحتياجات الغذائية خلال الحمل، بما في ذلك البروتين.
ماذا يحدث عند نقص البروتين؟
يتناول معظم الأشخاص في الولايات المتحدة كميات كافية من البروتين، بما في ذلك من يتبعون أنظمة غذائية نباتية. إلا أن انعدام الأمن الغذائي قد يؤدي إلى نقص البروتين، كما يُعد كبار السن أكثر عرضة لذلك مع ازدياد الاحتياجات مع التقدم في العمر.
ومن علامات نقص البروتين:
- مشكلات في الشعر والجلد والأظافر.
- زيادة الشهية.
- ارتفاع خطر الإصابة بالعدوى.
- تقلبات مزاجية.
- ضعف العضلات.